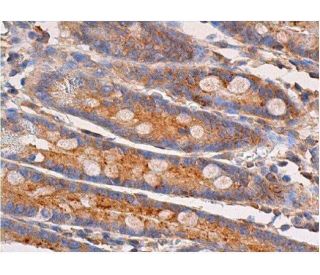

マイストア
変更
お店で受け取る
(送料無料)
配送する
納期目安:
2025.10.11 9:57頃のお届け予定です。
決済方法が、クレジット、代金引換の場合に限ります。その他の決済方法の場合はこちらをご確認ください。
※土・日・祝日の注文の場合や在庫状況によって、商品のお届けにお時間をいただく場合がございます。
fujisusakiページ p-p38 MAPK抗体(E-1) | SCBT - Santa Cruz Biotechnologyの詳細情報
p-p38 MAPK抗体(E-1) | SCBT - Santa Cruz Biotechnology。ZX-195X 公式限定フリースポーチ付 | ZEXUS公式サイト | ゼクサス。p-p38 MAPK抗体(E-1) | SCBT - Santa Cruz Biotechnology。
商品説明
*商品情報
新無処理CTPプレート「SUPERIA ZX」導入されたお客さまの声を
*iPhone8plus
スマートフォン本体 Xiaomi - Mi11lite 5g
【色】ピンクゴールド
Google Pixel - Google Pixel 4a 本体 SIMフリー
【キャリア】SoftBank
iPhone - iPhone12mini 64GB. Blue ジャンク品
【本体容量】64GB
富士通 - 【新品未使用】arrows m04 PREMIUM ホワイト
【バッテリー容量】84%
iPhone - iPhone SE2 (第2世代) 64GB ブラック
【ネットワーク利用制限の状況】○
Motorola - [バニラクリーム]MOTOROLA moto g64y 5G A401MO
【初期化】○
Galaxy - 【新品未使用】GALAXY A7 ギャラクシーA7 ブラック
【各ボタンの動作】○
iPhone - アップル iPhoneSE 第2世代 64GB ホワイト SIMフリーコード付き
【カメラ動作】○
iPhone - 【C】iPhone SE (第2世代)/64GB/356740118252999
【ライト動作】○
Apple - 動作良好 iPhone 8 ゴールド 256 GB SIMフリー 本体
【音・音量】○
iPhone - iPhoneXS 本体のみ SIMフリー
【水没】なし
SHARP - SHARP AQUOS wish4 SH-52E White 白 5G
【本体状態】ゲーム専用端末として、半年ほど問題なく使用しました。iPhone - iPhone SE 第2世代 (SE2) ホワイト。持ち歩かずスマホ用三脚にてゲームのみの使用で、外面に目立つ傷や汚れもなく綺麗な状態です!
iPhone - iPhone se2 64gb simフリー
動作不良や故障もなく、初期化済です。iPhone - 【C】iPhone SE (第2世代)/64GB/359230405302837。
Huawei P30 lite ブラック【箱付き/SIMフリー】
箱、付属品ありません。Galaxy - Galaxy A7 ブラック 64 GB SIMフリー。
iPhone - 【C】iPhone SE (第2世代)/64GB/356488109899424
*中古品ですので、ご理解お願いします。Xiaomi - Xiaomi (シャオミ) UQmobile版 Redmi 12 5G ポーラーシルバー 利用制限〇 SIMロックなし XIG03SSA 未使用品。
Galaxy - Galaxy A7 SIMフリー ブラック 64GB
新無処理CTPプレート「SUPERIA ZX」導入されたお客さまの声を
*iPhone8plus
スマートフォン本体 Xiaomi - Mi11lite 5g
【色】ピンクゴールド
Google Pixel - Google Pixel 4a 本体 SIMフリー
【キャリア】SoftBank
iPhone - iPhone12mini 64GB. Blue ジャンク品
【本体容量】64GB
富士通 - 【新品未使用】arrows m04 PREMIUM ホワイト
【バッテリー容量】84%
iPhone - iPhone SE2 (第2世代) 64GB ブラック
【ネットワーク利用制限の状況】○
Motorola - [バニラクリーム]MOTOROLA moto g64y 5G A401MO
【初期化】○
Galaxy - 【新品未使用】GALAXY A7 ギャラクシーA7 ブラック
【各ボタンの動作】○
iPhone - アップル iPhoneSE 第2世代 64GB ホワイト SIMフリーコード付き
【カメラ動作】○
iPhone - 【C】iPhone SE (第2世代)/64GB/356740118252999
【ライト動作】○
Apple - 動作良好 iPhone 8 ゴールド 256 GB SIMフリー 本体
【音・音量】○
iPhone - iPhoneXS 本体のみ SIMフリー
【水没】なし
SHARP - SHARP AQUOS wish4 SH-52E White 白 5G
【本体状態】ゲーム専用端末として、半年ほど問題なく使用しました。iPhone - iPhone SE 第2世代 (SE2) ホワイト。持ち歩かずスマホ用三脚にてゲームのみの使用で、外面に目立つ傷や汚れもなく綺麗な状態です!
iPhone - iPhone se2 64gb simフリー
動作不良や故障もなく、初期化済です。iPhone - 【C】iPhone SE (第2世代)/64GB/359230405302837。
Huawei P30 lite ブラック【箱付き/SIMフリー】
箱、付属品ありません。Galaxy - Galaxy A7 ブラック 64 GB SIMフリー。
iPhone - 【C】iPhone SE (第2世代)/64GB/356488109899424
*中古品ですので、ご理解お願いします。Xiaomi - Xiaomi (シャオミ) UQmobile版 Redmi 12 5G ポーラーシルバー 利用制限〇 SIMロックなし XIG03SSA 未使用品。
Galaxy - Galaxy A7 SIMフリー ブラック 64GB
商品情報
ベストセラーランキングです
近くの売り場の商品
カスタマーレビュー
オススメ度 4.6点
現在、2936件のレビューが投稿されています。